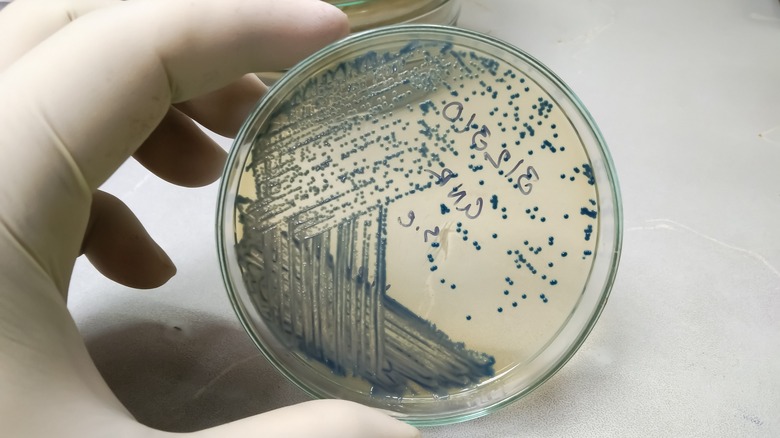

Which Carrots Are Affected By The E. Coli Recall? Here's What You Need To Know
On November 16, 2024, Grimmway Farms issued a massive recall on organic whole carrot and organic baby carrot products, due to the potential of Shiga toxin-producing E. coli contamination. According to a recall announcement by the FDA, the carrot products in question were distributed across the United States, Puerto Rico, and Canada, and sold by popular grocers including Trader Joe's, Target, Whole Foods, Sprouts, Wegmans, Walmart, Publix, and Kroger.
As of the time of this writing, the outbreak has caused illness in 39 people across 18 different states, including one death. These are only the cases that have been reported, and the FDA estimates that many more could be sick. After tracking reports of illness between the dates of September 6 and October 28, the CDC was able to connect the source of the E. coli to Grimmway Farms, which then issued a voluntary recall of all potentially contaminated products.
A full list of the recalled carrots can be found on the FDA recall announcement page, which includes specific brand names, bag sizes, and best-by dates. The affected products have been removed from shelves, but may still be residing in customers' kitchens. Grimmway is urging consumers to dispose of any recalled products immediately out of an abundance of caution.
The strain of E. coli affecting carrots is extra dangerous
In addition to throwing away affected products, anyone who has stocked potentially contaminated carrots in their refrigerator or freezer should completely clean and sanitize all surfaces in the appliance. The strain of E. coli connected to Grimmway Farms carrots is known to be particularly aggressive. Shiga toxin-producing E. Coli can cause a very serious type of food poisoning. Fever, nausea, stomach cramps, and indigestion are all common symptoms. Children, the immunocompromised, and the elderly are at higher risk for experiencing life-threatening symptoms that could result in hospitalization and even death. Symptoms can occur within 24 hours to ten days of ingesting contaminated food.
That being said, all strains of E. coli can be extremely dangerous to those who ingest them. In 2018, a strain of E. Coli linked to contaminated romaine lettuce was responsible for the deadliest outbreak in United States history. In October of 2024, E. coli connected to onions served at McDonald's caused 90 illnesses across 13 states, including 27 hospitalizations.
To lower your risk of contracting E. coli, be sure to toss out any products that are connected to a potential outbreak. Following proper food safety practices will also help to prevent sickness. If you do experience E. coli symptoms or consume potentially contaminated food, seek medical help right away.